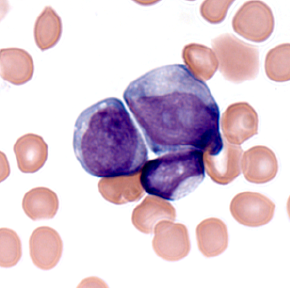

All publications
Main content
2023
Patients with Bacterial Sepsis Are Heterogeneous with Regard to Their Systemic Lipidomic Profiles.
Mosevoll KA, Hansen BA, Gundersen IM, Reikvam H, Bruserud Ø, Bruserud Ø, Wendelbo Ø.Metabolites. 2022 Dec 29;13(1):52. doi: 10.3390/metabo13010052.PMID: 36676977
Platelets for advanced drug delivery in cancer.
Cacic D, Hervig T, Reikvam H.Expert Opin Drug Deliv. 2023 May;20(5):673-688. doi: 10.1080/17425247.2023.2217378. Epub 2023 May 26.PMID: 37212640 Review.
Better and safer allogeneic stem cell transplantation.
Reikvam H.Tidsskr Nor Laegeforen. 2023 Mar 13;143(4). doi: 10.4045/tidsskr.23.0083. Print 2023 Mar 14.PMID: 36919289
Tuberculosis-Associated Hemophagocytic Lymphohistiocytosis: A Review of Current Literature.
Fauchald T, Blomberg B, Reikvam H.J Clin Med. 2023 Aug 18;12(16):5366. doi: 10.3390/jcm12165366.PMID: 37629407
Revisiting the prognostic role of FLT3 mutations in acute myelogenous leukemia.
Reikvam H.Expert Rev Hematol. 2023 May;16(5):317-323. doi: 10.1080/17474086.2023.2202849. Epub 2023 Apr 17.PMID: 37066885
Casein Kinase 2 (CK2): A Possible Therapeutic Target in Acute Myeloid Leukemia.
Bruserud Ø, Reikvam H.Cancers (Basel). 2023 Jul 21;15(14):3711. doi: 10.3390/cancers15143711.PMID: 37509370
Bruserud Ø, Mosevoll KA, Bruserud Ø, Reikvam H, Wendelbo Ø.Cells. 2023 Mar 24;12(7):1003. doi: 10.3390/cells12071003.PMID: 37048076
VEXAS Syndrome in a Patient with Myeloproliferative Neoplasia.
Austestad J, Madland TM, Sandnes M, Haslerud TM, Benneche A, Reikvam H.Case Rep Hematol. 2023 Feb 25;2023:6551544. doi: 10.1155/2023/6551544. eCollection 2023.PMID: 36879894
Reikvam H, Hetland G, Ezligini F, Dorsch K, Omert L, Dunham A, Almeland SK.Transfus Apher Sci. 2023 Jun 22:103755. doi: 10.1016/j.transci.2023.103755. Online ahead of print.PMID: 37423867
Erikstein BS, Ahmed AB, Forthun RB, Leh F, Gjertsen BT, Reikvam H.J Hematol. 2023 Apr;12(2):92-99. doi: 10.14740/jh1107. Epub 2023 Apr 30.PMID: 37187497
GM-CSF, Flt3-L and IL-4 affect viability and function of conventional dendritic cell types 1 and 2.
Lellahi SM, Azeem W, Hua Y, Gabriel B, Paulsen Rye K, Reikvam H, Kalland KH.Front Immunol. 2023 Jan 12;13:1058963. doi: 10.3389/fimmu.2022.1058963. eCollection 2022.PMID: 36713392
Reikvam H, Bruserud Ø, Hatfield KJ.Transplant Cell Ther. 2023 Jun;29(6):375.e1-375.e14. doi: 10.1016/j.jtct.2023.03.020. Epub 2023 Mar 24.PMID: 36966869
Mosevoll KA, Hansen BA, Gundersen IM, Reikvam H, Bruserud Ø, Bruserud Ø, Wendelbo Ø.Biomolecules. 2023 Jan 24;13(2):223. doi: 10.3390/biom13020223.PMID: 36830594
Lilleskare S, Vorland M, Vo AK, Aarsand AK, Reikvam H.Scand J Clin Lab Invest. 2023 Feb;83(1):3-7. doi: 10.1080/00365513.2022.2150984. Epub 2022 Dec 7.PMID: 36476017
En mann i 40-årene med transfusjonskrevende anemi.
Sandnes M, Helgeland L, Johansen S, Reikvam H.Tidsskr Nor Laegeforen. 2023 Oct 23;143(15). doi: 10.4045/tidsskr.23.0022. Print 2023 Oct 24.PMID: 37874056
Liposomal drug formulations for treatment of hematological malignancies.
Limi DC, Reikvam H.Expert Opin Pharmacother. 2023 Oct 12:1-4. doi: 10.1080/14656566.2023.2269086. Online ahead of print.PMID: 37823599
Platelets for advanced drug delivery in cancer.
Cacic D, Hervig T, Reikvam H.Expert Opin Drug Deliv. 2023 May;20(5):673-688. doi: 10.1080/17425247.2023.2217378. Epub 2023 May 26.PMID: 37212640
Iron Status and Physical Performance in Athletes.
Solberg A, Reikvam H.Life (Basel). 2023 Oct 2;13(10):2007. doi: 10.3390/life13102007.PMID: 37895389
Long-Smoldering T-prolymphocytic Leukemia: A Case Report and a Review of the Literature.
Gjelberg HK, Helgeland L, Liseth K, Micci F, Sandnes M, Russnes HG, Reikvam H.Curr Oncol. 2023 Nov 18;30(11):10007-10018. doi: 10.3390/curroncol30110727.PMID: 37999147
Bartaula-Brevik S, Leitch C, Hernandez-Valladares M, Aasebø E, Berven FS, Selheim F, Brenner AK, Rye KP, Hagen M, Reikvam H, McCormack E, Bruserud Ø, Tvedt THA.J Clin Med. 2023 Aug 25;12(17):5546. doi: 10.3390/jcm12175546.PMID: 37685612
Anette Lodvir Hemsing, Jan-Lukas Førde, Kristin Paulsen Rye, Håkon Reikvam, Lars Herfindal
Hemasphere. 2023 Aug; 7(Suppl ): e9915813. Published online 2023 Aug 8. doi: 10.1097/01.HS9.0000974012.99158.13
PMCID: PMC10430263
5612976 FIRST ADMINISTRATION OF HYPOXIC BLOOD IN A TRANSFUSION-DEPENDENT PATIENT
H. Reikvam, G. Hetland, F. Ezligini, K. Dorsch, A. Dunham, L. Omert, S. Almeland
Hemasphere. 2023 Apr; 7(Suppl ): 41. Published online 2023 Apr 10. doi: 10.1097/01.HS9.0000928440.72522.5d
PMCID: PMC10112628
2022
Holmemo HD, Reikvam H.Tidsskr Nor Laegeforen. 2021 Dec 22;141(1). doi: 10.4045/tidsskr.21.0695. Print 2022 Jan 11. PMID: 35026091
Eksamensformer i de norske medisinstudiene.
Raaheim OF, Raaheim DF, Reikvam H, Kvernenes M.Tidsskr Nor Laegeforen. 2022 Aug 12;142(11). doi: 10.4045/tidsskr.22.0337. Print 2022 Aug 16. PMID: 35997188
Sandnes M, Reikvam H.Tidsskr Nor Laegeforen. 2022 Jun 7;142(9). doi: 10.4045/tidsskr.22.0026. Print 2022 Jun 14 PMID: 3569955
Lymphoplasmacytic variant of multiple myeloma.
Johansen S, Gjelberg HK, Reikvam H.EJHaem. 2022 Apr 8;3(2):563-564. doi: 10.1002/jha2.437. eCollection 2022 May PMID: 35846062
Thrombosis and thrombocytopenia after HPV vaccination.
Johansen S, Laegreid IJ, Ernstsen SL, Azrakhsh NA, Kittang AO, Lindås R, Gjertsen BT, Vetti N, Mørtberg TV, Sørvoll IH, Holme PA, Ahlen MT, Reikvam H.J Thromb Haemost. 2022 Mar;20(3):700-704. doi: 10.1111/jth.15604. Epub 2021 Dec 7. PMID: 34817130
Proteomic approaches for untangling pharmacological targets in acute myelogenous leukemia.
Reikvam H, Hemsing AL, Hernandez-Valladares M, Birkeland E.Expert Rev Proteomics. 2022 Feb;19(2):73-76. doi: 10.1080/14789450.2022.2067530. Epub 2022 Apr 22. PMID: 35436165
MicroRNA serum profiles and chronic graft-versus-host disease.
Reikvam H, Vo AK, Johansen S, Hemsing AL, Solheim MH, Mosevoll KA, Tvedt THA, Hatfield KJ.Blood Adv. 2022 Sep 27;6(18):5295-5306. doi: 10.1182/bloodadvances.2021005930. PMID: 35443023
Autologous hematopoietic stem cell grafts - moving away from a one-size-fits-all approach.
Melve GK, Sandnes M, Reikvam H.Expert Rev Hematol. 2022 Jan;15(1):1-4. doi: 10.1080/17474086.2022.2022470. Epub 2022 Jan 6. PMID: 34949139
Rolsdorph LÅ, Mosevoll KA, Reikvam H.Expert Rev Hematol. 2022 Aug;15(8):667-670. doi: 10.1080/17474086.2022.2100341. Epub 2022 Jul 17. PMID: 35819263
Human papilloma virus vaccine and VITT antibody induction.
Kanack AJ, Laegreid IJ, Johansen S, Reikvam H, Ahlen MT, Padmanabhan A.Am J Hematol. 2022 Oct;97(10):E363-E364. doi: 10.1002/ajh.26659. Epub 2022 Aug 3. PMID: 35834243
Vo AK, Hervig T, Reikvam H.Expert Opin Investig Drugs. 2022 Sep;31(9):881-884. doi: 10.1080/13543784.2022.2113055. PMID: 35975626
Endocan in Acute Leukemia: Current Knowledge and Future Perspectives.
Reikvam H, Hatfield KJ, Wendelbo Ø, Lindås R, Lassalle P, Bruserud Ø.Biomolecules. 2022 Mar 24;12(4):492. doi: 10.3390/biom12040492.
Endocan in Acute Leukemia: Current Knowledge and Future Perspectives.
Reikvam H, Hatfield KJ, Wendelbo Ø, Lindås R, Lassalle P, Bruserud Ø.Biomolecules. 2022 Mar 24;12(4):492. doi: 10.3390/biom12040492. PMID: 35454082
Basosquamous Basal Cell Carcinoma with Bone Marrow Metastasis.
Thunestvedt LMØ, Helgeland L, Bachmann IM, Karlsdottir Å, Haslerud TM, Reikvam H.Curr Oncol. 2022 Mar 23;29(4):2193-2198. doi: 10.3390/curroncol29040178. PMID: 35448152
Limbic Encephalitis following Allogeneic Hematopoietic Stem Cell Transplantation.
Johansen S, Kråkenes J, Vedeler CA, Storstein AM, Reikvam H.Case Reports Immunol. 2022 Sep 10;2022:4174755. doi: 10.1155/2022/4174755. eCollection 2022 PMID: 36124252
NPM1-Mutated Patient-Derived AML Cells Are More Vulnerable to Rac1 Inhibition.
Hemsing AL, Rye KP, Hatfield KJ, Reikvam H.Biomedicines. 2022 Aug 4;10(8):1881. doi: 10.3390/biomedicines10081881. PMID: 36009428
Pretransplant Systemic Lipidomic Profiles in Allogeneic Stem Cell Transplant Recipients.
Hatfield KJ, Bruserud Ø, Reikvam H.Cancers (Basel). 2022 Jun 13;14(12):2910. doi: 10.3390/cancers14122910. PMID: 35740576
Toll-like Receptor 4, Osteoblasts and Leukemogenesis; the Lesson from Acute Myeloid Leukemia.
Bruserud Ø, Reikvam H, Brenner AK.Molecules. 2022 Jan 23;27(3):735. doi: 10.3390/molecules27030735. PMID: 35163998
Rolsdorph LÅ, Mosevoll KA, Helgeland L, Reikvam H.Front Med (Lausanne). 2022 Apr 19;9:819465. doi: 10.3389/fmed.2022.819465. eCollection 2022. PMID: 35514747
Kvinge AD, Kvammen T, Miletic H, Bindoff LA, Reikvam H.Curr Oncol. 2022 Nov 3;29(11):8415-8430. doi: 10.3390/curroncol29110663. PMID: 36354723
Johansen S, Blomberg B, Vo AK, Wendelbo Ø, Reikvam H.Cytotherapy. 2022 Dec;24(12):1190-1194. doi: 10.1016/j.jcyt.2022.08.006. Epub 2022 Sep 20. PMID: 36151003
Helland HK, Tylleskär T, Kvernenes M, Reikvam H.Healthcare (Basel). 2022 Jan 17;10(1):170. doi: 10.3390/healthcare10010170. PMID: 35052333
Lilleskare S, Vorland M, Vo AK, Aarsand AK, Reikvam H.Scand J Clin Lab Invest. 2022 Dec 7:1-5. doi: 10.1080/00365513.2022.2150984. Online ahead of print.PMID: 36476017
Heterogeneity of Patient-Derived Acute Myeloid Leukemia Cells Subjected to SYK In Vitro Inhibition.
Brattås MK, Hemsing AL, Rye KP, Hatfield KJ, Reikvam H.Int J Mol Sci. 2022 Nov 25;23(23):14706. doi: 10.3390/ijms232314706.PMID: 36499034
Vinnes EW, Hemsing AL.Tidsskr Nor Laegeforen. 2022 Nov 7;142(16). doi: 10.4045/tidsskr.22.0546. Print 2022 Nov 8.PMID: 36345642
2021
Thrombocytopaenia in the critically ill.
Bruserud Ø, Mosevoll KA, Kristoffersen E, Kvåle R, Reikvam H.Tidsskr Nor Laegeforen. 2021 Jan 11
Therapy for acute myelogenous leukemia revisited: moving away from a one-size-fits-all approach.
Reikvam H, Hemsing AL, Smith C.Expert Rev Anticancer Ther. 2021 Jan;21
Hyperferritinemia-A Clinical Overview.
Sandnes M, Ulvik RJ, Vorland M, Reikvam H.J Clin Med. 2021 May 7
Thrombosis and thrombocytopenia after HPV vaccination.
Johansen S, Laegreid IJ, Ernstsen SL, Azrakhsh NA, Kittang AO, Lindås R, Gjertsen BT, Vetti N, Mørtberg TV, Sørvoll IH, Holme PA, Ahlen MT, Reikvam H.J Thromb Haemost. 2021 Nov 24
Immunoglobulin-Storing Histiocytosis: A Case Based Systemic Review.
Wiese-Hansen H, Leh F, Lodvir Hemsing A, Reikvam H.J Clin Med. 2021 Apr
[A young woman with dyspnoea and proteinuria].
Hervig T, Tvedt THA, Knoop T, Sandnes M, Reikvam H.Tidsskr Nor Laegeforen. 2021 Nov
Tvedt THA, Vo AK, Bruserud Ø, Reikvam H.J Clin Med. 2021 Nov 6
Storhaug KØ, Skutlaberg DH, Hansen BA, Reikvam H, Wendelbo Ø.Antibiotics (Basel). 2021 Mar 19
Spontaneous Splenic Artery Rupture as the First Symptom of Systemic Amyloidosis.
Bruserud Ø, Tvedt THA, Ahmed AB, Vintermyr OK, Hervig T, Guttormsen AB, Reikvam H.Case Rep Crit Care. 2021 Mar 8
Bruserud Ø, Tsykunova G, Hernandez-Valladares M, Reikvam H, Tvedt THA.Pharmaceuticals (Basel). 2021 May 2
Cacic D, Reikvam H, Nordgård O, Meyer P, Hervig T.Cancers (Basel). 2021 Apr 14
Steinfeld PF, Knoop T, Trovik LH, Gjelberg HK, Haslerud TM, Reikvam H.Clin Pract. 2021 Jul 22
Sandnes M, Vorland M, Ulvik RJ, Reikvam H.Genes (Basel). 2021 Jul 28
Hatfield KJ, Grønningsaeter IS, Reikvam H.Curr Med Res Opin. 2021 Dec
Grønningsæter IS, Reikvam H, Aasebø E, Bartaula-Brevik S, Hernandez-Valladares M, Selheim F, Berven FS, Tvedt TH, Bruserud Ø, Hatfield KJ.J Pers Med. 2021 Aug
Aasebø E, Brenner AK, Hernandez-Valladares M, Birkeland E, Mjaavatten O, Reikvam H, Selheim F, Berven FS, Bruserud Ø.Diseases. 2021 Oct 16
Hernandez-Valladares M, Wangen R, Aasebø E, Reikvam H, Berven FS, Selheim F, Bruserud Ø.Cancers (Basel). 2021 Apr 29
Haaland I, Hjelle SM, Reikvam H, Sulen A, Ryningen A, McCormack E, Bruserud Ø, Gjertsen BT.Cells. 2021 Apr 7
Hemsing AL, Gjertsen BT, Spetalen S, Helgeland L, Reikvam H.SAGE Open Med Case Rep. 2021 Jan 22
Future perspective: precision medicine to improve treatment results in the settings of allogenic stem cell transplantation for acute myelogenous leukemia, Reikvam H, Johansen S, Koenecke C. Expert Review of Precision Medicine and Drug Development March 2021 6(2):1-5
Surgical Treatment of Severe Bowel Obstruction as a Rare Complication Following Allogenic Hematopoietic Stem Cell Transplantation. Reikvam H, Tvedt THA, Johansen, S, Aase Setran H, Havre RF. Transplantology 2020, 1, 102-110.
2020
Aasebø E, Berven FS, Hovland R, Døskeland SO, Bruserud Ø, Selheim F, Hernandez-Valladares M. Cancers (Basel). 2020 Jun 4;12(6):1466. doi: 10.3390/cancers12061466.
The PI3K-Akt-mTOR Signaling Pathway in Human Acute Myeloid Leukemia (AML) Cells.
Nepstad I, Hatfield KJ, Grønningsæter IS, Reikvam H. Int J Mol Sci. 2020 Apr 21;21(8):2907. doi: 10.3390/ijms21082907.
Proteome and Phosphoproteome Changes Associated with Prognosis in Acute Myeloid Leukemia.
Aasebø E, Berven FS, Bartaula-Brevik S, Stokowy T, Hovland R, Vaudel M, Døskeland SO, McCormack E, Batth TS, Olsen JV, Bruserud Ø, Selheim F, Hernandez-Valladares M. Cancers (Basel). 2020 Mar 17;12(3):709. doi: 10.3390/cancers12030709.
Tvedt THA, Skaarud KJ, Tjønnfjord GE, Gedde-Dahl T, Iversen PO, Bruserud Ø. Biol Blood Marrow Transplant. 2020 Feb;26(2):380-391. doi: 10.1016/j.bbmt.2019.10.005. Epub 2019 Oct 14.
Rundgren IM, Ryningen A, Anderson Tvedt TH, Bruserud Ø, Ersvær E. Molecules. 2020 Jan 16;25(2):367. doi: 10.3390/molecules25020367.
Febrile Neutropenia in Acute Leukemia. Epidemiology, Etiology, Pathophysiology and Treatment.
Hansen BA, Wendelbo Ø, Bruserud Ø, Hemsing AL, Mosevoll KA, Reikvam H. Mediterr J Hematol Infect Dis. 2020 Jan 1;12(1):e2020009. doi: 10.4084/MJHID.2020.009. eCollection 2020.
Probiotics to manage inflammation in HIV infection.
Reikvam DH, Meyer-Myklestad MH, Trøseid M, Stiksrud B. Curr Opin Infect Dis. 2020 Feb;33(1):34-43. doi: 10.1097/QCO.0000000000000612.
Hyperferritinemi-katarakt-syndrom.
Benneche A, Sandnes M, Bakke Å, Reikvam H. Tidsskr Nor Laegeforen. 2020 Nov 9;140(16). doi: 10.4045/tidsskr.20.0255. Print 2020 Nov 10.
Targeting Cellular Metabolism in Acute Myeloid Leukemia and The Role of Patient Heterogeneity.
Grønningsæter IS, Reikvam H, Aasebø E, Bartaula-Brevik S, Tvedt TH, Bruserud Ø, Hatfield KJ. Cells. 2020 May 7;9(5):1155. doi: 10.3390/cells9051155.
Therapy for acute myelogenous leukemia revisited: moving away from a one-size-fits-all approach.
Reikvam H, Hemsing AL, Smith C. Expert Rev Anticancer Ther. 2020 Oct 25:1-4. doi: 10.1080/14737140.2021.1838901.
COVID-19 and venous thromboembolism - prophylaxis and treatment.
Kvåle R, Azrakhsh NA, Mohn KG, Aanerud M, Guttormsen AB, Reikvam H. Tidsskr Nor Laegeforen. 2020 Jun 17;140(11). doi: 10.4045/tidsskr.20.0440.
Inhibition of NF-κB Signaling Alters Acute Myelogenous Leukemia Cell Transcriptomics.
Reikvam H. Cells. 2020 Jul 12;9(7):1677. doi: 10.3390/cells9071677.
Trovik LH, Sandnes M, Blomberg B, Holmaas G, Ahmed AB, Tvedt THA, Vintermyr O, Reikvam H. J Med Case Rep. 2020 Nov 11;14(1):217. doi: 10.1186/s13256-020-02555-x.
Bruserud Ø, Wendelbo Ø, Vetti N, Goplen FK, Johansen S, Reikvam H. Clin Pract. 2020 Jun 10;10(2):1214. doi: 10.4081/cp.2020.1214. eCollection 2020 May 19.
Pure Red Cell Aplasia with Del(20q) Sensitive for Immunosuppressive Treatment.
Vo AK, Kollsete Gjelberg H, Hovland R, Lindstad Brattås MK, Bruserud Ø, Reikvam H. Case Rep Hematol. 2020 Jan 20;2020:1262038. doi: 10.1155/2020/1262038. eCollection 2020.
Vo AK, Reikvam H, Midtbø H, Wirsching JL, Bruserud Ø, Wendelbo Ø. Case Rep Anesthesiol. 2020 Oct 15;2020:4219616. doi: 10.1155/2020/4219616. eCollection 2020.
Bruserud Ø, Engesæter IØ, Mjelle KE, Kristensen F, Wendelbo Ø. Tidsskr Nor Laegeforen. 2020 Sep 11;140(13). doi: 10.4045/tidsskr.20.0382. Print 2020 Sep 29.
Hernandez-Valladares M, Bruserud Ø, Selheim F. Int J Mol Sci. 2020 Sep 17;21(18):6830. doi: 10.3390/ijms21186830.
Bruserud Ø, Aarstad HH, Tvedt THA. Cancers (Basel). 2020 Jul 19;12(7):1966. doi: 10.3390/cancers12071966.
Bruserud Ø, Wendelbo Ø, Vetti N, Goplen FK, Johansen S, Reikvam H. Clin Pract. 2020 Jun 10;10(2):1214. doi: 10.4081/cp.2020.1214. eCollection 2020 May 19.
Serum levels of the IL-6 family of cytokines predict prognosis in renal cell carcinoma (RCC).
Gudbrandsdottir G, Aarstad HH, Bostad L, Hjelle KM, Aarstad HJ, Bruserud Ø, Tvedt THA, Beisland C. Cancer Immunol Immunother. 2020 Jul 3. doi: 10.1007/s00262-020-02655-z. Online ahead of print
Rundgren IM, Ersvær E, Ahmed AB, Ryningen A, Bruserud Ø. Medicina (Kaunas). 2020 Jan 18;56(1):36. doi: 10.3390/medicina56010036.
Aarstad HH, Guðbrandsdottir G, Hjelle KM, Bostad L, Bruserud Ø, Tvedt THA, Beisland C. Cancers (Basel). 2020 Jul 19;12(7):1961. doi: 10.3390/cancers12071961.
Aarstad HH, Moe SEE, Bruserud Ø, Lybak S, Aarstad HJ, Tvedt THA. Biomedicines. 2020 Oct 14;8(10):418. doi: 10.3390/biomedicines8100418.
Vo AK, Reikvam H, Midtbø H, Wirsching JL, Bruserud Ø, Wendelbo Ø. Case Rep Anesthesiol. 2020 Oct 15;2020:4219616. doi: 10.1155/2020/4219616. eCollection 2020.
Cold agglutinin disease revisited: a multinational, observational study of 232 patients.
Berentsen S, Barcellini W, D'Sa S, Randen U, Tvedt THA, Fattizzo B, Haukås E, Kell M, Brudevold R, Dahm AEA, Dalgaard J, Frøen H, Hallstensen RF, Jæger PH, Hjorth-Hansen H, Małecka A, Oksman M, Rolke J, Sekhar M, Sørbø JH, Tjønnfjord E, Tsykunova G, Tjønnfjord GE. Blood. 2020 Jul 23;136(4):480-488. doi: 10.1182/blood.2020005674.
Michel M, Ruggeri M, Gonzalez-Lopez TJ, Alkindi SS, Cheze S, Ghanima W, Tvedt THA, Ebbo M, Terriou L, Bussel JB, Godeau B. Blood. 2020 Aug 19:blood.2020007594. doi: 10.1182/blood.2020007594.
2019
BMC Immunol. 2019 Nov 8;20(1):39. doi: 10.1186/s12865-019-0323-y.
Rundgren IM1,2, Ersvær E1, Ahmed AB3, Ryningen A1, Bruserud Ø4,5.
Cells. 2019 Oct 10;8(10). pii: E1229. doi: 10.3390/cells8101229.
Grønningsæter IS1,2, Fredly HK3, Gjertsen BT4,5, Hatfield KJ6,7, Bruserud Ø8,9.
Cancers (Basel). 2019 Jul 11;11(7). pii: E973. doi: 10.3390/cancers11070973.
Brenner AK1,2, Bruserud Ø3,4.
J Clin Med. 2019 Jul 4;8(7). pii: E970. doi: 10.3390/jcm8070970.
Reikvam H1,2, Aasebø E3, Brenner AK4, Bartaula-Brevik S3, Grønningsæter IS4, Forthun RB4, Hovland R5,6, Bruserud Ø3,4.
J Cancer Res Clin Oncol. 2019 Jul;145(7):1729-1749. doi: 10.1007/s00432-019-02931-1. Epub 2019 May 20.
Modulation of phospho-proteins by interferon-alpha and valproic acid in acute myeloid leukemia.
Forthun RB1, Hellesøy M2, Sulen A1, Kopperud RK1, Sjøholt G3, Bruserud Ø2,4, McCormack E1,2, Gjertsen BT5,6.
Signal Transduct Target Ther. 2019 Jun 19;4:20. doi: 10.1038/s41392-019-0050-0. eCollection 2019.
Nepstad I1, Hatfield KJ1,2, Grønningsæter IS1, Aasebø E1,3, Hernandez-Valladares M1,3, Hagen KM1, Rye KP1, Berven FS3, Selheim F3, Reikvam H1,4, Bruserud Ø1,4.
Tidsskr Nor Laegeforen. 2019 Apr 26;139(8). doi: 10.4045/tidsskr.18.0775. Print 2019 May 7.
Treatment of acute myeloid leukaemia in elderly patients.
[Article in Norwegian]
Reikvam H, Dalgaard J, Johansen S, Tvedt THA, Bruserud Ø.
Expert Opin Investig Drugs. 2019 Mar 27:1-10. doi: 10.1080/13543784.2019.1597052. [Epub ahead of print]
Brattås MK1, Reikvam H2, Tvedt THA2, Bruserud Ø2,3.
Curr Med Chem. 2019 Mar 24. doi: 10.2174/0929867326666190325095853. [Epub ahead of print]
Leufven E1, Bruserud O2.
Mol Cancer Ther. 2019 Mar;18(3):567-578. doi: 10.1158/1535-7163.MCT-17-1234. Epub 2019 Jan 24.
Bjørnstad R1,2, Aesoy R1, Bruserud Ø3, Brenner AK3, Giraud F4, Dowling TH5, Gausdal G6, Moreau P4, Døskeland SO7, Anizon F4, Herfindal L8.
Expert Rev Hematol. 2019 Feb;12(2):119-128. doi: 10.1080/17474086.2019.1570126. Epub 2019 Jan 28.
Skaadel H1, Bruserud Ø1,2.
Cancers (Basel). 2019 Jan 10;11(1). pii: E73. doi: 10.3390/cancers11010073.
Brenner AK1,2, Aasebø E3,4, Hernandez-Valladares M5,6, Selheim F7, Berven F8, Grønningsæter IS9,10, Bartaula-Brevik S11, Bruserud Ø12,13.
2018
Neoplasia. 2018 Dec;20(12):1175-1186. doi: 10.1016/j.neo.2018.09.007. Epub 2018 Oct 23.
S100 Proteins in Acute Myeloid Leukemia.
Brenner AK1, Bruserud Ø2.
Proteomes. 2018 Dec 20;7(1). pii: E1. doi: 10.3390/proteomes7010001.
Aasebø E1,2, Hernandez-Valladares M3,4, Selheim F5, Berven FS6, Brenner AK7,8, Bruserud Ø9,10
Biomark Res. 2018 Nov 21;6:33. doi: 10.1186/s40364-018-0147-6. eCollection 2018.
Philadelphia chromosome positive AML arising from JAK2-positive myelofibrosis.
Brattås MK1, Lilleeng K1, Hovland R2, Lægreid IJ3, Vorland M4, Leh F5, Bruserud Ø6,7, Gjertsen BT6,7, Reikvam H6,7.
J Immunol Methods. 2018 Oct;461:53-62. doi: 10.1016/j.jim.2018.06.003. Epub 2018 Jun 12.
Rundgren IM1, Bruserud Ø2, Ryningen A3, Ersvær E4.
Case Rep Hematol. 2018 Sep 23;2018:2045985. doi: 10.1155/2018/2045985. eCollection 2018.
Chronic Myeloid Leukemia Relapsing 25 Years after Allogenic Stem Cell Transplantation.
Reikvam H1,2, Skavland J1, Gullaksen SE1, Hovland R3, Gedde-Dahl T4,5, Bruserud Ø1,2, Gjertsen BT1,2.
Int J Mol Sci. 2018 Sep 22;19(10). pii: E2886. doi: 10.3390/ijms19102886.
Tvedt THA1,2, Melve GK3,4, Tsykunova G5, Ahmed AB6, Brenner AK7, Bruserud Ø8,9.
Cancers (Basel). 2018 Sep 14;10(9). pii: E332. doi: 10.3390/cancers10090332.
Nepstad I1, Hatfield KJ2,3, Tvedt THA4, Reikvam H5,6, Bruserud Ø7,8.
Vox Sang. 2018 Aug 29. doi: 10.1111/vox.12703. [Epub ahead of print]
Wendelbo Ø1, Opheim EN2, Hervig T1,3, Felli Lunde TH2, Bruserud Ø1,3, Mollnes TE4,5,6,7,8, Reikvam H1,3.
Expert Rev Hematol. 2018 Aug 20:1-3. doi: 10.1080/17474086.2018.1511420. [Epub ahead of print]
Bruserud Ø1,2, Melve GK3, Gedde-Dahl T4, Tvedt THA2.
Oxf Med Case Reports. 2018 Jul 3;2018(7):omy038. doi: 10.1093/omcr/omy038. eCollection 2018 Jul.
Successful eradication of leptomeningeal plasma cell disease.
Bruserud Ø1, Hansen BA2, Vetti N3,4, Johansen S5, Reikvam H5,6.
J Immunol Methods. 2018 Jun 12. pii: S0022-1759(17)30510-0. doi: 10.1016/j.jim.2018.06.003. [Epub ahead of print]
Rundgren IM1, Bruserud Ø2, Ryningen A3, Ersvær E4.
Clin Pract. 2018 Jun 7;8(2):1061. doi: 10.4081/cp.2018.1061. eCollection 2018 Mar 28.
Grønningsæter IS1,2, Ahmed AB2, Vetti N1,3, Johansen S2, Bruserud Ø1,2, Reikvam H1,2.
Clin Exp Immunol. 2018 Mar 7. doi: 10.1111/cei.13124. [Epub ahead of print]
Tvedt THA1,2, Hovland R3, Tsykunova G1, Ahmed AB1, Gedde-Dahl T4, Bruserud Ø1,2.
Cytotherapy. 2018 May;20(5):740-754. doi: 10.1016/j.jcyt.2018.02.366. Epub 2018 Mar 22.
Melve GK1, Ersvaer E2, Paulsen Rye K3, Bushra Ahmed A4, Kristoffersen EK5, Hervig T5, Reikvam H6, Hatfield KJ5, Bruserud Ø6.
Expert Opin Investig Drugs. 2018 Apr;27(4):377-387. doi: 10.1080/13543784.2018.1459562. Epub 2018 Apr 4.
Splenic tyrosine kinase (SYK) inhibitors and their possible use in acute myeloid leukemia.
Bartaula-Brevik S1, Lindstad Brattås MK2, Tvedt THA1,3, Reikvam H1,3, Bruserud Ø1,3.
Front Immunol. 2018 Apr 6;9:691. doi: 10.3389/fimmu.2018.00691. eCollection 2018.
Inflammatory Mediator Profiles Differ in Sepsis Patients With and Without Bacteremia.
Mosevoll KA1,2, Skrede S1,2, Markussen DL2, Fanebust HR3, Flaatten HK4, Aßmus J5, Reikvam H1,2, Bruserud Ø1,2.
Case Rep Oncol Med. 2018 Feb 28;2018:7697283. doi: 10.1155/2018/7697283. eCollection 2018.
Johansen S1, Kollsete Gjelberg H2, Ahmed AB1, Bruserud Ø1,3, Reikvam H1,3.
Front Immunol. 2018 May 2;9:845. doi: 10.3389/fimmu.2018.00845. eCollection 2018.
Melve GK1,2, Ersvaer E3, Eide GE4,5, Kristoffersen EK1,2, Bruserud Ø2,6.
Front Med (Lausanne). 2018 May 22;5:147. doi: 10.3389/fmed.2018.00147. eCollection 2018.
Mosevoll KA1, Johansen S1, Wendelbo Ø1, Nepstad I1, Bruserud Ø1,2, Reikvam H1,2.
Expert Opin Ther Targets. 2018 Jun 11. doi: 10.1080/14728222.2018.1487401. [Epub ahead of print]
Nepstad I1, Hatfield KJ1,2, Aasebø E3, Hernandez-Valladares M3, Brenner AK1, Bartaula-Brevik S1, Berven F3, Selheim F3, Skavland J1, Gjertsen BT1, Reikvam H1,4, Bruserud Ø1,4.
Int J Mol Sci. 2018 Jan 27;19(2). pii: E382. doi: 10.3390/ijms19020382.
Nepstad I1, Reikvam H2, Brenner AK3,4, Bruserud Ø5,6, Hatfield KJ7,8.
Front Immunol. 2018 Jan 24;8:1979. doi: 10.3389/fimmu.2017.01979. eCollection 2017.
Reikvam H1,2, Grønningsæter IS1,2, Mosevoll KA1,2, Lindås R1, Hatfield K2, Bruserud Ø1,2.
Int J Mol Sci. 2018 Jan 19;19(1). pii: E296. doi: 10.3390/ijms19010296.
Wangen R1,2, Aasebø E3,4, Trentani A5, Døskeland SO6, Bruserud Ø7, Selheim F8,9, Hernandez-Valladares M10,11.
Int J Mol Sci. 2018 Jan 15;19(1). pii: E251. doi: 10.3390/ijms19010251.
Johansen S1, Brenner AK2,3, Bartaula-Brevik S4, Reikvam H5,6, Bruserud Ø7,8.
2017
J Proteomics. 2017 Nov 21. pii: S1874-3919(17)30394-9. doi: 10.1016/j.jprot.2017.11.014. [Epub ahead of print]
Forthun RB1, Aasebø E2, Rasinger JD3, Bedringaas SL1, Berven F4, Selheim F4, Bruserud Ø5, Gjertsen BT6.
Expert Rev Hematol. 2017 Nov 23:1-12. doi: 10.1080/17474086.2018.1407239. [Epub ahead of print]
Vacuolar ATPase as a possible therapeutic target in human acute myeloid leukemia.
Aasebø E1,2, Bartaula-Brevik S1, Hernandez-Valladares M1,2, Bruserud Ø1,3.
Expert Opin Drug Discov. 2017 Oct;12(10):1053-1065. doi: 10.1080/17460441.2017.1356818. Epub 2017 Jul 27.
Bruserud Ø1,2, Aasebø E1,3, Hernandez-Valladares M1,3, Tsykunova G2, Reikvam H2.
J Cancer Res Clin Oncol. 2017 Oct;143(10):1985-1998. doi: 10.1007/s00432-017-2458-7. Epub 2017 Jun 19.
The constitutive protease release by primary human acute myeloid leukemia cells.
Honnemyr M1, Bruserud Ø2,3, Brenner AK1,4.
BMC Cancer. 2017 Sep 6;17(1):630. doi: 10.1186/s12885-017-3620-y.
Reikvam H1, Hovland R2, Forthun RB3, Erdal S2, Gjertsen BT3, Fredly H3, Bruserud Ø3.
Expert Rev Proteomics. 2017 Aug;14(8):649-663. doi: 10.1080/14789450.2017.1352474. Epub 2017 Jul 27.
Hernandez-Valladares M1,2, Vaudel M3,4, Selheim F2, Berven F2, Bruserud Ø1.
Front Immunol. 2017 Jun 8;8:667. doi: 10.3389/fimmu.2017.00667. eCollection 2017.
Tvedt THA1,2, Ersvaer E3, Tveita AA4, Bruserud Ø1,2.
Expert Rev Clin Immunol. 2017 Jun;13(6):553-569. doi: 10.1080/1744666X.2017.1279053. Epub 2017 Jan 17.
Grønningsæter IS1,2, Tsykunova G1, Lilleeng K1, Ahmed AB1, Bruserud Ø1,2, Reikvam H3.
Leuk Lymphoma. 2017 Jun;58(6):1494-1497. doi: 10.1080/10428194.2016.1243682. Epub 2016 Oct 14.
Rethinking the role of osteopontin in human acute myeloid leukemia.
Brenner AK1, Aasebø E2, Hernandez-Valladares M2, Selheim F2, Berven F2, Bruserud Ø1,3.
Expert Opin Ther Targets. 2017 Apr;21(4):357-369. doi: 10.1080/14728222.2017.1300255. Epub 2017 Mar 3.
Brenner AK1, Tvedt TH1, Nepstad I1, Rye KP1, Hagen KM1, Reikvam H1,2, Bruserud Ø1,2.
Molecules. 2017 Mar 11;22(3). pii: E446. doi: 10.3390/molecules22030446.
Brenner AK1, Reikvam H2, Rye KP3, Hagen KM4, Lavecchia A5, Bruserud Ø6,7.
Expert Opin Investig Drugs. 2017 Mar;26(3):343-355. doi: 10.1080/13543784.2017.1275564. Epub 2016 Dec 28.
Tvedt TH1, Nepstad I2, Bruserud Ø1,2.
Front Immunol. 2017 Feb 9;8:106. doi: 10.3389/fimmu.2017.00106. eCollection 2017.
Brenner AK1, Nepstad I1, Bruserud Ø2.
BMC Immunol. 2017 Jan 28;18(1):5. doi: 10.1186/s12865-017-0190-3.
Giardia-specific cellular immune responses in post-giardiasis chronic fatigue syndrome.
Hanevik K1,2, Kristoffersen E3,4, Mørch K3,5, Rye KP3, Sørnes S3, Svärd S6, Bruserud Ø3, Langeland N3,5.
Metabolomics. 2017;13(1):2. Epub 2016 Nov 28.
Granulocyte colony-stimulating factor alters the systemic metabolomic profile in healthy donors.
Hatfield KJ1, Melve GK1, Bruserud Ø2.
2016
Curr Pharm Biotechnol. 2016;17(1):52-70.
Aasebø E, Forthun RB, Berven F, Selheim F, Hernandez-Valladares M1.
Oncotarget. 2016 Dec 10. doi: 10.18632/oncotarget.13853. [Epub ahead of print]
Omsland M1, Bruserud Ø2,3, Gjertsen BT1,3, Andresen V1.
Tidsskr Nor Laegeforen. 2016 Dec 6;136(22):1889-1894. eCollection 2016 Dec.
Myeloproliferative neoplasms and JAK2 mutations.
[Article in English, Norwegian]
Almedal H1, Vorland M2, Aarsand AK3, Grønningsæter IS4, Bruserud Ø4, Reikvam H5.
Cell Death Dis. 2016 Dec 1;7(12):e2497. doi: 10.1038/cddis.2016.392.
Andresen V1, Erikstein BS1, Mukherjee H2, Sulen A1, Popa M3,4, Sørnes S5, Reikvam H5, Chan KP2,6, Hovland R7, McCormack E4,5, Bruserud Ø4,5, Myers AG2, Gjertsen BT1,4.
Metabolomics. 2016;12(1):12. Epub 2015 Nov 16.
Reikvam H1, Hatfield K2, Bruserud Ø1.
Int J Mol Sci. 2016 Nov 1;17(11). pii: E1823.
Tvedt TH1, Lie SA2, Reikvam H3,4, Rye KP5, Lindås R6, Gedde-Dahl T7, Ahmed AB8, Bruserud Ø9,10.
Molecules. 2016 Nov 11;21(11). pii: E1512.
Brenner AK1, Andersson Tvedt TH2,3, Bruserud Ø4,5.
Cancer Immunol Immunother. 2016 Sep;65(9):1135-47. doi: 10.1007/s00262-016-1865-y. Epub 2016 Aug 1.
Reduced potency of cytotoxic T lymphocytes from patients with high-risk myelodysplastic syndromes.
Sand K1, Theorell J2, Bruserud Ø1,3, Bryceson YT1,2, Kittang AO4,5.
Proteomes. 2016 Aug 22;4(3). pii: E24. doi: 10.3390/proteomes4030024.
Hernandez-Valladares M1, Aasebø E2, Selheim F3, Berven FS4, Bruserud Ø5.
J Proteomics. 2016 Aug 11;145:214-25. doi: 10.1016/j.jprot.2016.03.049. Epub 2016 Apr 20.
Aasebø E1, Mjaavatten O2, Vaudel M3, Farag Y4, Selheim F5, Berven F6, Bruserud Ø7, Hernandez-Valladares M8.
Int J Mol Sci. 2016 Jul 19;17(7). pii: E1158. doi: 10.3390/ijms17071158.
Melve GK1,2, Ersvaer E3, Akkök ÇA4, Ahmed AB5, Kristoffersen EK6,7, Hervig T8,9, Bruserud Ø10,11.
Int J Mol Sci. 2016 Jul 5;17(7). pii: E1080. doi: 10.3390/ijms17071080.
The Systemic Profile of Soluble Immune Mediators in Patients with Myelodysplastic Syndromes.
Kittang AO1,2, Sand K3, Brenner AK4, Rye KP5, Bruserud Ø6,7.
Biol Proced Online. 2016 Jun 21;18:13. doi: 10.1186/s12575-016-0043-0. eCollection 2016.
Hernandez-Valladares M1, Aasebø E1, Mjaavatten O1, Vaudel M1, Bruserud Ø2, Berven F1, Selheim F1.
Oncoimmunology. 2015 Jun 24;5(2):e1062208. eCollection 2016 Feb.
Kittang AO1, Kordasti S2, Sand KE3, Costantini B2, Kramer AM2, Perezabellan P2, Seidl T2, Rye KP3, Hagen KM3, Kulasekararaj A2, Bruserud Ø3, Mufti GJ2.
Front Immunol. 2016 May 25;7:205. doi: 10.3389/fimmu.2016.00205. eCollection 2016.
Brenner AK1, Reikvam H2, Bruserud Ø3.
Eur J Haematol. 2016 Mar;96(3):211-21. doi: 10.1111/ejh.12690. Epub 2015 Nov 26.
Hauge M1, Bruserud Ø1,2, Hatfield KJ1.
Cytotherapy. 2016 Feb;18(2):172-85. doi: 10.1016/j.jcyt.2015.11.010.
Kallekleiv M1, Larun L2, Bruserud Ø3, Hatfield KJ4.
Oncotarget. 2016 Jan 23. doi: 10.18632/oncotarget.6991. [Epub ahead of print]
Hydroxyurea synergizes with valproic acid in wild-type p53 acute myeloid leukaemia.
Leitch C1,2, Osdal T1, Andresen V1,2, Molland M1, Kristiansen S1, Nguyen XN1, Bruserud Ø1,3, Gjertsen BT1,2,3, McCormack E1,3.
Curr Pharm Biotechnol. 2016;17(1):6-19.
The Past, Present and Future Subclassification of Patients with Acute Myeloid Leukemia.
Forthun RB1, Hinrichs C, Dowling TH, Bruserud Ø, Selheim F.
Curr Pharm Biotechnol. 2016;17(1):92-104.
Nutrition in Allogeneic Stem Cell Transplantion--Clinical Guidelines and Immunobiological Aspects.
Tvedt TH, Reikvam H, Bruserud Ø1.
Cytotherapy. 2016 Feb;18(2):172-85. doi: 10.1016/j.jcyt.2015.11.010.
Kallekleiv M1, Larun L2, Bruserud Ø3, Hatfield KJ4.
Oncotarget. 2016 Jan 23. doi: 10.18632/oncotarget.6991. [Epub ahead of print]
Hydroxyurea synergizes with valproic acid in wild-type p53 acute myeloid leukaemia.
Leitch C1,2, Osdal T1, Andresen V1,2, Molland M1, Kristiansen S1, Nguyen XN1, Bruserud Ø1,3, Gjertsen BT1,2,3, McCormack E1,3.
2015
Dis Markers. 2015;2015:943430. doi: 10.1155/2015/943430. Epub 2015 Nov 2.
Reikvam H1, Grønningsæter IS2, Ahmed AB2, Hatfield K2, Bruserud Ø1.
Eur J Haematol. 2015 Oct 14. doi: 10.1111/ejh.12690. [Epub ahead of print]
Hauge M1, Bruserud Ø1,2, Hatfield KJ1.
Curr Pharm Biotechnol. 2015 Sep 30. [Epub ahead of print]
NUTRITION IN ALLOGENEIC STEM CELL TRANSPLANTION - CLINICAL GUIDELINES AND IMMUNOBIOLOGICAL ASPECTS.
Tvedt TH, Reikvam H, Bruserud Ø1.
Stem Cell Res. 2015 Sep 25;15(3):530-541. doi: 10.1016/j.scr.2015.09.008. [Epub ahead of print]
Reikvam H1, Brenner AK2, Hagen KM2, Liseth K3, Skrede S4, Hatfield KJ2, Bruserud Ø5.
Curr Pharm Biotechnol. 2015 Sep 7. [Epub ahead of print]
The Past, Present and Future Subclassification of Patients with Acute Myeloid Leukemia.
Forthun RB1, Hinrichs C, Dowling TH, Bruserud O, Selheim F.
Thromb Res. 2015 Jul;136(1):30-9. doi: 10.1016/j.thromres.2015.04.002. Epub 2015 Apr 11.
Mosevoll KA1, Lindås R2, Tvedt TH2, Bruserud Ø3, Reikvam H4.
Blood Coagul Fibrinolysis. 2015 Jun;26(4):469-72. doi: 10.1097/MBC.0000000000000255.
A 35-year-old woman with influenza A-associated thrombotic thrombocytopenic purpura.
Jonsson MK1, Hammenfors D, Oppegaard O, Bruserud Ø, Kittang AO.
Cell Rep. 2015 Jun 9;11(9):1446-57. doi: 10.1016/j.celrep.2015.04.063. Epub 2015 May 21.
Co-activation of AMPK and mTORC1 Induces Cytotoxicity in Acute Myeloid Leukemia.
Sujobert P1, Poulain L1, Paubelle E2, Zylbersztejn F2, Grenier A1, Lambert M1, Townsend EC3, Brusq JM4, Nicodeme E4, Decrooqc J2, Nepstad I5, Green AS1, Mondesir J1, Hospital MA1, Jacque N1, Christodoulou A3, Desouza TA3, Hermine O2, Foretz M6, Viollet B6, Lacombe C1, Mayeux P1, Weinstock DM3, Moura IC2, Bouscary D1, Tamburini J7.
Expert Rev Hematol. 2015 Jun;8(3):299-313. doi: 10.1586/17474086.2015.1032935. Epub 2015 Apr 3.
Reikvam H1, Hauge M, Brenner AK, Hatfield KJ, Bruserud Ø.
Expert Rev Hematol. 2015 Jun;8(3):315-27. doi: 10.1586/17474086.2015.1036025. Epub 2015 Apr 22.
Reikvam H1, Hoang TT, Bruserud Ø.
BMC Pharmacol Toxicol. 2015 May 2;16:12. doi: 10.1186/s40360-015-0012-2.
Ersvaer E1,2, Brenner AK3, Vetås K4, Reikvam H5, Bruserud Ø6,7.
J Immunol Methods. 2015 Mar;418:19-28. doi: 10.1016/j.jim.2015.01.006. Epub 2015 Jan 28.
Tvedt TH1, Rye KP2, Reikvam H3, Brenner AK3, Bruserud Ø4.
Int J Mol Med. 2015 Mar;35(3):645-52. doi: 10.3892/ijmm.2014.2045. Epub 2014 Dec 19.
Reikvam H1, Ryningen A1, Sæterdal LR2, Nepstad I1, Foss B2, Bruserud Ø1.
Oncotarget. 2015 Feb 20;6(5):2794-811.
Bruserud Ø1,2, Reikvam H1,2, Fredly H1,2, Skavland J2, Hagen KM1, van Hoang TT1, Brenner AK1, Kadi A3,4,5, Astori A3,4,5, Gjertsen BT1,2, Pendino F6,3,4,5.
Expert Rev Hematol. 2015 Feb;8(1):29-41. doi: 10.1586/17474086.2015.971005. Epub 2014 Nov 6.
STAT3 as a possible therapeutic target in human malignancies: lessons from acute myeloid leukemia.
2014
J Immunol. 2014 Dec 15;193(12):6192-206. doi: 10.4049/jimmunol.1400859. Epub 2014 Nov 7.
Gras Navarro A1, Kmiecik J1, Leiss L2, Zelkowski M1, Engelsen A1, Bruserud Ø3, Zimmer J4, Enger PØ2, Chekenya M5.
Molecules. 2014 Nov 12;19(11):18414-47. doi: 10.3390/molecules191118414.
Brenner AK1, Reikvam H1, Lavecchia A2, Bruserud Ø3.
J Transplant. 2014;2014:404096. doi: 10.1155/2014/404096. Epub 2014 Oct 8.
Lindås R1, Tvedt TH1, Hatfield KJ2, Reikvam H1, Bruserud O3.
Cell Stem Cell. 2014 Oct 2;15(4):431-46. doi: 10.1016/j.stem.2014.08.001.
Li L1, Osdal T2, Ho Y1, Chun S1, McDonald T1, Agarwal P1, Lin A1, Chu S1, Qi J1, Li L1, Hsieh YT1, Dos Santos C1, Yuan H3, Ha TQ2, Popa M4, Hovland R5, Bruserud O6, Gjertsen BT6, Kuo YH1, Chen W3, Lain S7, McCormack E8, Bhatia R9.
Springerplus. 2014 Sep 30;3:571. doi: 10.1186/2193-1801-3-571. eCollection 2014.
Mosevoll KA1, Lindås R2, Wendelbo O3, Bruserud O4, Reikvam H2.
Expert Opin Ther Targets. 2014 Sep 9:1-15. [Epub ahead of print]
Hatfield KJ, Reikvam H, Bruserud O.
Proteomics. 2014 Sep;14(17-18):1971-6. doi: 10.1002/pmic.201300448. Epub 2014 Aug 8.
Aasebø E, Vaudel M, Mjaavatten O, Gausdal G, Van der Burgh A, Gjertsen BT, Døskeland SO, Bruserud O, Berven FS, Selheim F.
Cancer Immunol Immunother. 2014 Aug;63(8):757-77. doi: 10.1007/s00262-014-1578-z. Epub 2014 Jul 5.
Bruserud Ø, Tvedt TH, Paulsen PQ, Ahmed AB, Gedde-Dahl T, Tjønnfjord GE, Slåstad H, Heldal D, Reikvam H.
Expert Opin Ther Targets. 2014 Aug;18(8):929-44. doi: 10.1517/14728222.2014.924925. Epub 2014 Jun 24.
Reikvam H, Brenner AK, Nepstad I, Sulen A, Bruserud Ø.
Oncoscience. 2014 Aug 6;1(8):529-39. eCollection 2014.
Hampson P1, Wang K2, Ersvær E3, McCormack E3, Schüler J4, Fiebig HH4, Gjertsen BT3, Bruserud Ø3, Lord JM1.
Tidsskrift for den Norske laegeforening 2014 May 27;134:1052-5. Norwegian.
Akutt promyelocyttleukemi. [Article in Norwegian]
Reikvam H, Hovland R, Bruserud O.
Tidsskr Nor Laegeforen. 2014 May 27;134(10):1058-61. doi: 10.4045/tidsskr.13.0817. eCollection 2014.
[A man in his 80s with muscle stiffness and skin bleeding]. [Article in Norwegian]
Tvedt TH, Holme PA, Bruserud Ø.
Mol Cancer. 2014 May 21;13:116. doi: 10.1186/1476-4598-13-116.
Haaland I, Opsahl JA, Berven FS, Reikvam H, Fredly HK, Haugse R, Thiede B, McCormack E, Lain S, Bruserud O, Gjertsen BT.
Leukemia. 2014 Feb 27. doi: 10.1038/leu.2014.89. [Epub ahead of print]
Novel activating STAT5B mutations as putative drivers of T-cell acute lymphoblastic leukemia.
Kontro M, Kuusanmäki H, Eldfors S, Burmeister T, Andersson EI, Bruserud O, Brümmendorf TH, Edgren H, Gjertsen BT, Itälä-Remes M, Lagsrtöm S, Lohi O, Lundán T, Martí JM, Majumder MM, Parsons A, Pemovska T, Rajala H, Vettenranta K, Kallioniemi O, Mustjoki S, Porkka K, Heckman CA.
Leuk Res Treatment. 2014;2014:143479. doi: 10.1155/2014/143479. Epub 2014 Jan 8.
Kvestad H, Evensen L, Lorens JB, Bruserud O, Hatfield KJ.
Br J Haematol. 2014 Jan;164(2):200-11. doi: 10.1111/bjh.12611. Epub 2013 Oct 23.
Reikvam H, Tamburini J, Skrede S, Holdhus R, Poulain L, Ersvaer E, Hatfield KJ, Bruserud O.
Blood Transfus. 2013 Oct 24:1-6. doi: 10.2450/2013.0303-12. [Epub ahead of print]
Nepstad I, Reikvam H, Strandenes G, Hess JR, Apelseth TO, Hervig TA.
2013
Expert Opin Investig Drugs. 2013 Nov;22(11):1365-70. doi: 10.1517/13543784.2013.841137. Epub 2013 Oct 7.
Reikvam H, Nepstad I, Tamburini J.
Cell Prolif. 2013 Oct;46(5):554-62. doi: 10.1111/cpr.12057.
Reikvam H, Øyan AM, Kalland KH, Hovland R, Hatfield KJ, Bruserud Ø.
Oncotarget. 2013 Sep;4(9):1438-48.
Astori A, Fredly H, Aloysius TA, Bullinger L, Mansat-De Mas V, de la Grange P, Delhommeau F, Hagen KM, Récher C, Dusanter-Fourt I, Knappskog S, Lillehaug JR, Pendino F, Bruserud Ø.
Oncotarget. 2013 Jun;4(6):830-43.
Reikvam H, Nepstad I, Bruserud Ø, Hatfield KJ.
Transfus Med. 2013 Dec;23(6):397-406. doi: 10.1111/tme.12067. Epub 2013 Aug 6.
Bruserud O, Liseth K, Stamnesfet S, Cacic DL, Melve G, Kristoffersen E, Hervig T, Reikvam H.
Clin Epigenetics. 2013 Aug 1;5(1):13. doi: 10.1186/1868-7083-5-13.
Fredly H, Ersvær E, Kittang AO, Tsykunova G, Gjertsen BT, Bruserud O.
Clin Epigenetics. 2013 Jul 30;5(1):12. doi: 10.1186/1868-7083-5-12.
Fredly H, Gjertsen BT, Bruserud O.
BMC Pharmacol Toxicol. 2013 Jul 11;14:35. doi: 10.1186/2050-6511-14-35.
Bredholt T, Ersvær E, Erikstein BS, Sulen A, Reikvam H, Aarstad HJ, Johannessen AC, Vintermyr OK, Bruserud Ø, Gjertsen BT.
Cytotherapy. 2013 Apr 24. pii: S1465-3249(13)00409-X. doi: 10.1016/j.jcyt.2013.02.008. [Epub ahead of print]
Mosevoll KA, Akkök CA, Hervig T, Melve GK, Bruserud O, Reikvam H.
Expert Opin Investig Drugs. 2013 May;22(5):551-63. doi: 10.1517/13543784.2013.791280.
Reikvam H, Nepstad I, Sulen A, Gjertsen BT, Hatfield KJ, Bruserud Ø.
Oncoimmunology. 2013 Feb 1;2(2):e23138.
Sand KE, Rye KP, Mannsåker B, Bruserud O, Kittang AO.
Cell Death Dis. 2013 Feb 28;4:e516. doi: 10.1038/cddis.2013.39.
Gausdal G, Wergeland A, Skavland J, Nguyen E, Pendino F, Rouhee N, McCormack E, Herfindal L, Kleppe R, Havemann U, Schwede F, Bruserud O, Gjertsen BT, Lanotte M, Ségal-Bendirdjian E, Døskeland SO.
Blood. 2013 Feb 14;121(7):e34-42. doi: 10.1182/blood-2012-05-429555. Epub 2012 Dec 12.
Multiplexed mAbs: a new strategy in preclinical time-domain imaging of acute myeloid leukemia.
McCormack E, Mujić M, Osdal T, Bruserud Ø, Gjertsen BT.
Oncoimmunology. 2013 Feb 1;2(2):e23138.
Sand KE, Rye KP, Mannsåker B, Bruserud O, Kittang AO.
Toxins (Basel). 2013 Feb 18;5(2):336-62. doi: 10.3390/toxins5020336.
Reikvam H, Fredly H, Kittang AO, Bruserud O.
Mar Drugs. 2013 Jan 30;11(2):332-49. doi: 10.3390/md11020332.
Myhren LE, Nygaard G, Gausdal G, Sletta H, Teigen K, Degnes KF, Zahlsen K, Brunsvik A, Bruserud O, Døskeland SO, Selheim F, Herfindal L.
Curr Cancer Drug Targets. 2013 Jan;13(1):30-47.
Reikvam H, Kittang AO, Melve G, Mosevoll KA, Bentsen PT, Ersvær E, Gjertsen BT, Bruserud Ø.
2012
Eur Cytokine Netw. 2012 Nov 1;23(4):140-53. doi: 10.1684/ecn.2012.0322.
Reikvam H, Hatfield KJ, Fredly H, Nepstad I, Mosevoll KA, Bruserud O.
Blood. 2013 Feb 14;121(7):e34-42. doi: 10.1182/blood-2012-05-429555. Epub 2012 Dec 12.
Multiplexed mAbs: a new strategy in preclinical time-domain imaging of acute myeloid leukemia.
McCormack E, Mujic M, Osdal T, Bruserud O, Gjertsen BT.
Bone Marrow Res. 2012;2012:329061. doi: 10.1155/2012/329061. Epub 2012 Oct 2.
Ryningen A, Reikvam H, Nepstad I, Paulsen Rye K, Bruserud O.
Cancer Chemother Pharmacol. 2012 Oct 6. [Epub ahead of print]
High-dose etoposide in allogeneic stem cell transplantation.
Bruserud O, Reikvam H, Kittang AO, Ahmed AB, Tvedt TH, Sjo M, Hatfield KJ.
Eur J Haematol. 2012 Oct 9. doi: 10.1111/ejh.12016. [Epub ahead of print]
Soluble mediators released by acute myeloid leukemia cells increase capillary-like networks.
Hatfield KJ, Evensen L, Reikvam H, Lorens JB, Bruserud O.
Curr Cancer Drug Targets. 2012 Aug 2. [Epub ahead of print]
Reikvam H, Kittang AO, Melve G, Mosevoll KA, Bentsen PT, Ersvær E, Gjertsen BT, Bruserud O.
Blood. 2012 Jul 26;120(4):847-57. Epub 2012 Jun 12.
Lång E, Grudic A, Pankiv S, Bruserud O, Simonsen A, Bjerkvig R, Bjørås M, Bøe SO.
Expert Opin Investig Drugs. 2012 May;21(5):587-603. Epub 2012 Mar 17.
Tsykunova G, Reikvam H, Ahmed AB, Nepstad I, Gjertsen BT, Bruserud O.
Leukemia. 2012 Apr;26(4):563-71. doi: 10.1038/leu.2011.314. Epub 2011 Nov 11.
Venous thromboembolism in patients with essential thrombocythemia and polycythemia vera.
Reikvam H, Tiu RV.
Am J Hematol. 2012 Apr;87(4):368-76. doi: 10.1002/ajh.23116. Epub 2012 Feb 28.
Fredly H, Reikvam H, Gjertsen BT, Bruserud O.
Br J Haematol. 2012 Feb;156(4):468-80. doi: 10.1111/j.1365-2141.2011.08960.x. Epub 2011 Dec 13.
Reikvam H, Hatfield KJ, Ersvaer E, Hovland R, Skavland J, Gjertsen BT, Petersen K, Bruserud O.
Leukemia. 2012 May;26(5):910-7. doi: 10.1038/leu.2011.315. Epub 2011 Nov 8.
McCormack E, Haaland I, Venås G, Forthun RB, Huseby S, Gausdal G, Knappskog S, Micklem DR, Lorens JB, Bruserud O, Gjertsen BT.
Biol Blood Marrow Transplant. 2012 Feb;18(2):190-9. doi: 10.1016/j.bbmt.2011.10.007. Epub 2011 Oct 20.
Reikvam H, Mosevoll KA, Melve GK, Günther CC, Sjo M, Bentsen PT, Bruserud Ø.
Leukemia. 2012 Mar;26(3):557-9. doi: 10.1038/leu.2011.243. Epub 2011 Sep 9.
Tsykunova G, Reikvam H, Hovland R, Bruserud Ø.
Oncogene. 2012 Mar 22;31(12):1533-45. doi: 10.1038/onc.2011.348. Epub 2011 Aug 22.
Ånensen N, Hjelle SM, Van Belle W, Haaland I, Silden E, Bourdon JC, Hovland R, Taskén K, Knappskog S, Lønning PE, Bruserud Ø, Gjertsen BT.
2011
Leukemia. 2012 Apr;26(4):563-71. doi: 10.1038/leu.2011.314. Epub 2011 Nov 11.
Venous thromboembolism in patients with essential thrombocythemia and polycythemia vera.
Reikvam H, Tiu RV.
Hematology. 2011 Nov;16(6):351-6.
Hatfield KJ, Lassalle P, Leiva RA, Lindås R, Wendelboe Ø, Bruserud Ø.
Bone Marrow Res. 2011;2011:570796. Epub 2010 Oct 4.
Ersvaer E, Hatfield KJ, Reikvam H, Bruserud O.
Biol Blood Marrow Transplant. 2012 Feb;18(2):190-9. Epub 2011 Oct 20.
Reikvam H, Mosevoll KA, Melve GK, Günther CC, Sjo M, Bentsen PT, Bruserud Ø.
J Infect Dis. 2011 Dec;204(11):1779-86. Epub 2011 Oct 11.
Human cellular immune response against Giardia lamblia 5 years after acute giardiasis.
Hanevik K, Kristoffersen E, Svard S, Bruserud O, Ringqvist E, Sørnes S, Langeland N.
Cancer Immunol Immunother. 2011 Dec;60(12):1669-81. Epub 2011 Oct 12.
Ersvær E, Melve GK, Bruserud O.
Expert Rev Hematol. 2011 Oct;4(5):563-76.
The chemokine system in allogeneic stem-cell transplantation: a possible therapeutic target?
Melve GK, Ersvssr E, Kittang AO, Bruserud O.
Cytotherapy. 2011 Nov;13(10):1259-68. doi: 10.3109/14653249.2011.605117. Epub 2011 Sep 12.
Akkök CA, Hervig T, Stamnesfet S, Nesthus I, Melve GK, Lassalle P, Bruserud O.
Leuk Res. 2011 Sep;35(9):1156-8. Epub 2011 Jul 30.
Bruserud Ø, Hatfield KJ, Reikvam H.
J Biomed Biotechnol. 2011;2011:104631. Epub 2011 May 3.
Reikvam H, Hatfield KJ, Kittang AO, Hovland R, Bruserud Ø.
Cytotherapy. 2011 Sep;13(8):1013-24. Epub 2011 Apr 20.
Akkök CA, Liseth K, Melve GK, Ersvaer E, Hervig T, Bruserud Ø.
Oncol Rep. 2011 Jun;25(6):1549-56. doi: 10.3892/or.2011.1229. Epub 2011 Mar 22.
Fredly H, Ersvær E, Gjertsen BT, Bruserud O.
Eur Cytokine Netw. 2011 Mar;22(1):52-62.
Apelseth TO, Hervig T, Wentzel-Larsen T, Petersen K, Reikvam H, Bruserud Ø.
Blood Rev. 2011 May;25(3):113-22. Epub 2011 Feb 12.
Apelseth TO, Hervig T, Bruserud O.
Blood Cancer J. 2011 Feb;1(2):e4. doi: 10.1038/bcj.2011.2. Epub 2011 Feb 11.
Skavland J, Jørgensen KM, Hadziavdic K, Hovland R, Jonassen I, Bruserud O, Gjertsen BT.
J Proteomics. 2011 Mar 1;74(3):269-81. Epub 2010 Nov 12.
Jørgensen KM, Hjelle SM, Øye OK, Puntervoll P, Reikvam H, Skavland J, Anderssen E, Bruserud Ø, Gjertsen BT.
2010
Curr Med Chem. 2010;17(36):4448-61.
Hatfield KJ, Reikvam H, Bruserud Ø.
Curr Top Microbiol Immunol. 2010;341:v-vi.
The chemokine system in experimental and clinical hematology. Preface.
Bruserud Ø.
Expert Opin Ther Targets. 2010 Nov;14(11):1139-42.
Bruserud Ø, Reikvam H.
Hematology. 2010 Oct;15(5):338-43.
Fredly H, Stapnes Bjørnsen C, Gjertsen BT, Bruserud Ø.
Blood. 2010 Sep 2;116(9):1389-90.
Antivascular combo therapy: up-and-coming.
Bruserud O, Hatfield K.
Eur Cytokine Netw. 2010 Sep;21(3):154-64. Epub 2010 Aug 20.
Hatfield KJ, Bedringsaas SL, Ryningen A, Gjertsen BT, Bruserud O.
Leuk Res. 2010 Nov;34(11):1422-3. Epub 2010 Jul 16.
Heat shock protein 90 (HSP90) inhibition--from experimental to clinical studies.
Bruserud Ø, Reikvam H.
J Biomed Biotechnol. 2010;2010:692097. Epub 2010 Jun 2.
Liseth K, Ersvaer E, Hervig T, Bruserud Ø.
BMC Immunol. 2010 Jul 9;11:38.
Ersvaer E, Liseth K, Skavland J, Gjertsen BT, Bruserud Ø.
Genome Med. 2010 Jun 29;2(6):41.
Clinical proteomics of myeloid leukemia.
Hjelle SM, Forthun RB, Haaland I, Reikvam H, Sjøholt G, Bruserud O, Gjertsen BT.
Nutr Cancer. 2010;62(5):574-83.
McCormack E, Skavland J, Mujic M, Bruserud Ø, Gjertsen BT.
Transfus Apher Sci. 2010 Aug;43(1):33-6. Epub 2010 Jun 16.
Akkök CA, Hervig T, Bjørsvik S, Underdal MO, Skoug CF, Ersvaer E, Bruserud Ø.
Apoptosis. 2010 Aug;15(8):946-55.
Hampson P, Wang K, Milverton L, Ersvaer E, Bruserud O, Lord JM.
Curr Top Microbiol Immunol. 2010;341:149-72.
Kittang AO, Hatfield K, Sand K, Reikvam H, Bruserud Ø.
Curr Top Microbiol Immunol. 2010;341:3-12.
The chemokine system in experimental and clinical hematology.
Bruserud Ø, Kittang AO.
Eur Cytokine Netw. 2010 Mar;21(1):40-9.
Liseth K, Sjo M, Paulsen K, Bruserud Ø, Ersvaer E.
Expert Opin Investig Drugs. 2010 Feb;19(2):169-83.
Reikvam H, Hatfield KJ, Lassalle P, Kittang AO, Ersvaer E, Bruserud Ø.
Toxins (Basel). 2010 Jan;2(1):174-94. Epub 2010 Jan 22.
Ersvaer E, Kittang AO, Hampson P, Sand K, Gjertsen BT, Lord JM, Bruserud O.
Transfusion. 2010 Apr;50(4):766-75. Epub 2009 Dec 18.
Apelseth TO, Bruserud O, Wentzel-Larsen T, Hervig T.
Eur J Haematol. 2010 Mar;84(3):239-51. Epub 2009 Nov 17.
Reikvam H, Hatfield KJ, Oyan AM, Kalland KH, Kittang AO, Bruserud O.
Biochim Biophys Acta. 2010 Jan;1798(1):1-8. Epub 2009 Oct 31.
Connexin-based signaling in acute myelogenous leukemia (AML).
Foss B, Tronstad KJ, Bruserud Ø.
2009
Crit Rev Oncog. 2009;15(1-2):1-41.
Reikvam H, Olsnes AM, Gjertsen BT, Ersvar E, Bruserud Ø.
J BUON. 2009 Sep;14 Suppl 1:S131-40.
Olsnes AM, Hatfield KJ, Bruserud Ø.
Crit Rev Oncog. 2009;15(1):1-36.
Nuclear Factor-kappaB Signaling: A Contributor in Leukemogenesis and a Target for Pharmacological Intervention in Human Acute Myelogenous Leukemia.
Reikvam H, Olsnes AM, Gjertsen BT, Ersvar E, Bruserud O.
Cytotherapy. 2009;11(6):749-60.
Use of different DMSO concentrations for cryopreservation of autologous peripheral blood stem cell grafts does not have any major impact on levels of leukocyte- and platelet-derived soluble mediators.
Akkök CA, Liseth K, Hervig T, Ryningen A, Bruserud Ø, Ersvaer E.
Curr Cancer Drug Targets. 2009 Sep;9(6):761-76.
Heat shock protein 90 - a potential target in the treatment of human acute myelogenous leukemia.
Reikvam H, Ersvaer E, Bruserud O.
Hematology. 2009 Aug;14(4):224-6. doi: 10.1179/102453309X439782.
Bruserud Ø, Håvardstein K.
Transfusion. 2009 Aug;49(8):1709-19.
Liseth K, Ersvær E, Abrahamsen JF, Nesthus I, Ryningen A, Bruserud Ø.
Br J Haematol. 2009 Jun;145(6):761-74. Epub 2009 Apr 20.
Olsnes AM, Ersvaer E, Ryningen A, Paulsen K, Hampson P, Lord JM, Gjertsen BT, Kristoffersen EK, Bruserud Ø.
Stem Cells Dev. 2009 Jul-Aug;18(6):807-12.
Connexins are active participants of hematopoietic stem cell regulation.
Foss B, Hervig T, Bruserud O.
Expert Opin Investig Drugs. 2009 Apr;18(4):433-55.
Targeted therapy in acute myeloid leukaemia: current status and future directions.
Stapnes C, Gjertsen BT, Reikvam H, Bruserud Ø.
BMC Cancer. 2009 Mar 5;9:77.
Øyan AM, Anensen N, Bø TH, Stordrange L, Jonassen I, Bruserud Ø, Kalland KH, Gjertsen BT.
Tidsskr Nor Laegeforen. 2009 Feb 26;129(5):416-9.
[Granulocyte transfusion]. [Article in Norwegian]
Reikvam H, Blom US, Kristoffersen E, Liseth K, Bruserud O, Hervig T.
Br J Haematol. 2009 Jan;144(1):53-68. Epub 2008 Oct 30.
Hatfield K, Øyan AM, Ersvaer E, Kalland KH, Lassalle P, Gjertsen BT, Bruserud Ø.
Leuk Res. 2009 Jun;33(6):779-87. Epub 2008 Nov 12.
Ryningen A, Stapnes C, Lassalle P, Corbascio M, Gjertsen BT, Bruserud O.
Transfusion. 2009 Feb;49(2):354-61. Epub 2008 Oct 28.
Akkök CA, Holte MR, Tangen JM, Ostenstad B, Bruserud O.
2008
Curr Cancer Drug Targets. 2008 Dec;8(8):666-75.
Anticancer immunotherapy in combination with proapoptotic therapy.
Bruserud Ø, Ersvaer E, Olsnes A, Gjertsen BT.
Hematology. 2008 Dec;13(6):329-32.
Olsnes AM, Ersvaer E, Ryningen A, Bruserud O.
Expert Opin Investig Drugs. 2008 Nov;17(11):1623-33.
In vivo biological effects of ATRA in the treatment of AML.
Ryningen A, Stapnes C, Paulsen K, Lassalle P, Gjertsen BT, Bruserud O.
J Interferon Cytokine Res. 2008 May;28(5):297-310.
Olsnes AM, Ryningen A, Ersvaer E, Bruserud Ø.
Transfusion. 2008 May;48(5):877-83. Epub 2008 Feb 21.
Akkök CA, Liseth K, Nesthus I, Løkeland T, Tefre K, Bruserud O, Abrahamsen JF.
Platelets. 2008 Mar;19(2):155-9.
Platelet-released supernatants enhance hematopoietic stem cell proliferation in vitro.
Foss B, Bruserud O, Hervig T.
Oncogene. 2008 Jun 19;27(27):3765-79. doi: 10.1038/onc.2008.16. Epub 2008 Feb 11.
Review: genetic models of acute myeloid leukaemia.
McCormack E, Bruserud O, Gjertsen BT.
Thromb Haemost. 2008 Jan;99(1):27-37.
Platelet functions and clinical effects in acute myelogenous leukemia.
Foss B, Bruserud O.
Blood. 2008 Mar 1;111(5):2866-77. Epub 2008 Jan 8.
Gausdal G, Gjertsen BT, McCormack E, Van Damme P, Hovland R, Krakstad C, Bruserud Ø, Gevaert K, Vandekerckhove J, Døskeland SO.
Leukemia. 2008 Feb;22(2):287-93. Epub 2007 Oct 18.
Hatfield KJ, Hovland R, Øyan AM, Kalland KH, Ryningen A, Gjertsen BT, Bruserud Ø.
2007
Curr Pharm Biotechnol. 2007 Dec;8(6):401-11.
Ryningen A, Bruserud Ø.
Curr Pharm Biotechnol. 2007 Dec;8(6):344-54.
Oyan AM, Bø TH, Jonassen I, Ulvestad E, Tore Gjertsen B, Bruserud O, Kalland KH.
Curr Pharm Biotechnol. 2007 Dec;8(6):318-9.
Introduction: RNA and the treatment of human cancer.
Bruserud O.
Int J Oncol. 2007 Dec;31(6):1529-38.
Stapnes C, Ryningen A, Hatfield K, Øyan AM, Eide GE, Corbascio M, Kalland KH, Gjertsen BT, Bruserud Ø.
Expert Opin Ther Targets. 2007 Aug;11(8):1055-69.
Hagland H, Nikolaisen J, Hodneland LI, Gjertsen BT, Bruserud Ø, Tronstad KJ.
Eur J Haematol. 2007 Sep;79(3):210-25. Epub 2007 Jul 26.
Ersvaer E, Zhang JY, McCormack E, Olsnes A, Anensen N, Tan EM, Gjertsen BT, Bruserud O.
Hematology. 2007 Jun;12(3):199-207.
Ersvaer E, Hampson P, Wendelbo Ø, Lord JM, Gjertsen BT, Bruserud Ø.
Mol Cancer. 2007 May 11;6:33.
Wergeland L, Sjøholt G, Haaland I, Hovland R, Bruserud Ø, Gjertsen BT.
Expert Rev Anticancer Ther. 2007 May;7(5):741-51.
Early gene expression of acute myeloid leukemia in response to chemotherapy.
Anensen N, Øyan AM, Huseby S, Kalland KH, Bruserud Ø, Gjertsen BT.
Mol Cancer. 2007 Apr 23;6:31.
Huang TS, Myklebust LM, Kjarland E, Gjertsen BT, Pendino F, Bruserud Ø, Døskeland SO, Lillehaug JR.
Anal Biochem. 2007 Jul 1;366(1):46-58. Epub 2007 Mar 18.
Petersen K, Oyan AM, Rostad K, Olsen S, Bø TH, Salvesen HB, Gjertsen BT, Bruserud O, Halvorsen OJ, Akslen LA, Steen VM, Jonassen I, Kalland KH.
Leuk Res. 2007 Sep;31(9):1303-13. Epub 2007 Apr 9.
Ryningen A, Stapnes C, Bruserud Ø.
Transfusion. 2007 Apr;47(4):653-65.
Apelseth TØ, Bruserud Ø, Wentzel-Larsen T, Bakken AM, Bjørsvik S, Hervig T.
Br J Haematol. 2007 Mar;136(6):814-28.
Stapnes C, Døskeland AP, Hatfield K, Ersvaer E, Ryningen A, Lorens JB, Gjertsen BT, Bruserud O.
Haematologica. 2007 Mar;92(3):332-41.
Bruserud Ø, Ryningen A, Olsnes AM, Stordrange L, Øyan AM, Kalland KH, Gjertsen BT.
Cancer Immunol Immunother. 2007 Jun;56(6):913-25. Epub 2006 Nov 8.
Ersvaer E, Hampson P, Hatfield K, Ulvestad E, Wendelbo Ø, Lord JM, Gjertsen BT, Bruserud Ø.
Blood. 2007 Mar 15;109(6):2589-96. Epub 2006 Nov 14.
Irish JM, Anensen N, Hovland R, Skavland J, Børresen-Dale AL, Bruserud O, Nolan GP, Gjertsen BT.
Cancer Immunol Immunother. 2007 Jan;56(1):13-24. Epub 2006 Apr 13.
Effects of interferon gamma on native human acute myelogenous leukaemia cells.
Ersvaer E, Skavland J, Ulvestad E, Gjertsen BT, Bruserud Ø.
2006
Platelets. 2006 Aug;17(5):296-302.
Ryningen A, Apelseth T, Hausken T, Bruserud Ø.
Int J Cancer. 2006 Nov 15;119(10):2313-21.
Hatfield K, Ryningen A, Corbascio M, Bruserud O.
Clin Cancer Res. 2006 Jul 1;12(13):3985-92.
Anensen N, Oyan AM, Bourdon JC, Kalland KH, Bruserud O, Gjertsen BT.
Transfusion. 2006 May;46(5):800-10.
Apelseth TO, Hervig TA, Wentzel-Larsen T, Bruserud O.
Acta Oncol. 2006;45(3):346-9.
Stapnes C, Ryningen A, Gjertsen BT, Bruserud Ø.
Cancer. 2006 Jun 1;106(11):2397-405.
Samuelsson J, Hasselbalch H, Bruserud O, Temerinac S, Brandberg Y, Merup M, Linder O, Bjorkholm M, Pahl HL, Birgegard G; Nordic Study Group for Myeloproliferative Disorders.
Cancer Immunol Immunother. 2007 Jan;56(1):13-24. Epub 2006Apr 13.
Effects of interferon gamma on native human acute myelogenous leukaemia cells.
Ersvaer E, Skavland J, Ulvestad E, Gjertsen BT, Bruserud Ø.
BMC Bioinformatics. 2006 Apr 10;7:198.
Van Belle W, Anensen N, Haaland I, Bruserud Ø, Høgda KA, Gjertsen BT.
Leuk Res. 2006 Dec;30(12):1531-40. Epub 2006 Apr 5.
Ryningen A, Ersvaer E, Øyan AM, Kalland KH, Vintermyr OK, Gjertsen BT, Bruserud Ø.
Int J Oncol. 2006 May;28(5):1065-80.
Øyan AM, Bø TH, Jonassen I, Gjertsen BT, Bruserud Ø, Kalland KH.
Expert Opin Ther Targets. 2006 Feb;10(1):51-68.
Bruserud Ø, Stapnes C, Tronstad KJ, Ryningen A, Anensen N, Gjertsen BT.
Leukemia. 2006 Apr;20(4):734-6.
Anensen N, Skavland J, Stapnes C, Ryningen A, Børresen-Dale AL, Gjertsen BT, Bruserud Ø.
Cancer Immunol Immunother. 2006 Jul;55(7):830-40. Epub 2005 Nov 3.
Olsnes AM, Motorin D, Ryningen A, Zaritskey AY, Bruserud Ø.
Cancer Immunol Immunother. 2006 Feb;55(2):221-8. Epub 2005 Jul 21.
Is targeted chemotherapy an alternative to immunotherapy in chronic lymphocytic leukemia?
Bruserud Ø, Tronstad KJ, McCormack E, Gjertsen BT.
Cancer Immunol Immunother. 2006 Feb;55(2):185-7. Epub 2005 Jul 7.
Immunotherapy in chronic lymphocytic leukemia.
Bruserud Ø, McCormack E, Gjertsen BT.
2005
Scand J Clin Lab Invest. 2005;65(6):505-11.
Bruserud O, Grovan F, Lindås R, Blymke Møinichen C, Osterhus KK.
Curr Drug Targets. 2005 Sep;6(6):631-46.
Sjøholt G, Anensen N, Wergeland L, Mc Cormack E, Bruserud Ø, Gjertsen BT.
Cytotherapy. 2005;7(4):328-33.
Liseth K, Abrahamsen JF, Bjørsvik S, Grøttebø K, Bruserud Ø.
Curr Cancer Drug Targets. 2005 Jun;5(4):229-48.
Hatfield KJ, Olsnes AM, Gjertsen BT, Bruserud Ø.
J Cancer Res Clin Oncol. 2005 Jun;131(6):377-84. Epub 2005 Mar 18.
Bruserud O, Tronstad KJ, Berge R.
Cytometry B Clin Cytom. 2005 Mar;64(1):18-27.
Oyan AM, Bø TH, Jonassen I, Ulvestad E, Gjertsen BT, Kalland KH, Bruserud O.
Transfusion. 2005 Feb;45(2):248-53.
Abrahamsen JF, Stamnesfet S, Liseth K, Hervig T, Bruserud O.
Eur J Haematol. 2005 Jan;74(1):24-34.
Glenjen NI, Hatfield K, Bruserud Ø.
Leuk Res. 2005 Feb;29(2):185-96.
Ryningen A, Wergeland L, Glenjen N, Gjertsen BT, Bruserud O.
2004
Cytotherapy. 2004;6(4):356-62.
Abrahamsen JF, Wentzel-Larsen T, Bruserud O.
Eur J Haematol. 2004 Nov;73(5):340-50.
Bruserud Ø, Wendelbo Ø, Paulsen K.
Int J Cancer. 2004 Oct 10;111(6):858-67.
In vitro effects of native human acute myelogenous leukemia blasts on fibroblasts and osteoblasts.
Glenjen N, Ersvaer E, Ryningen A, Bruserud Ø.
Cell. 2004 Jul 23;118(2):217-28.
Single cell profiling of potentiated phospho-protein networks in cancer cells.
Irish JM, Hovland R, Krutzik PO, Perez OD, Bruserud Ø, Gjertsen BT, Nolan GP.
Scand J Immunol. 2004 Jul-Aug;60(1-2):189-98.
Ersvaer E, Bertelsen LT, Espenes LC, Bredholt T, Bøe SO, Iversen BM, Bruserud Ø, Ulvestad E, Gjertsen BT.
Cancer Immunol Immunother. 2004 Aug;53(8):740-7. Epub 2004 May 5.
Wendelbo Ø, Nesthus I, Sjo M, Paulsen K, Ernst P, Bruserud Ø.
Transfusion. 2004 May;44(5):785-9.
Abrahamsen JF, Rusten L, Bakken AM, Bruserud Ø.
Haematologica. 2004 Apr;89(4):391-402.
Bruserud Ø, Ryningen A, Wergeland L, Glenjen NI, Gjertsen BT.
Cancer Immunol Immunother. 2004 Aug;53(8):677-80. Epub 2004 Apr 7.
How should clinical data be included in experimental studies of cancer immunology?
Gjertsen BT, Bruserud Ø.
Leuk Res. 2004 May;28(5):461-8.
Wendelbo Ø, Nesthus I, Sjo M, Ernst P, Bruserud Ø.
2003
J Hematother Stem Cell Res. 2003 Oct;12(5):525-35.
Wendelbo Ø, Bruserud Ø.
Hematology. 2003 Oct;8(5):313-8.
Motorin D, Bakken A, Foss Abrahamsen J, Ernst P, Bruserud Ø.
Expert Opin Ther Targets. 2003 Oct;7(5):663-77.
Modified fatty acids and their possible therapeutic targets in malignant diseases.
Tronstad KJ, Berge K, Berge RK, Bruserud Ø.
Eur J Haematol. 2003 Sep;71(3):163-73.
Glenjen N, Hovland R, Wergeland L, Wendelbo Ø, Ernst P, Bruserud Ø.
J Hematother Stem Cell Res. 2003 Jun;12(3):351-8.
Bakken AM, Bruserud O, Abrahamsen JF.
Eur J Haematol. 2003 Jul;71(1):9-17.
Bruserud Ø, Glenjen N, Ryningen A.
Haematologica. 2003 Apr;88(4):416-28.
Bruserud Ø, Hovland R, Wergeland L, Huang TS, Gjertsen BT.
Cancer Immunol Immunother. 2003 Apr;52(4):215-25. Epub 2003 Feb 15.
Bruserud O, Ulvestad E.
Leuk Res. 2003 May;27(5):455-64.
Bruserud Ø, Glenjen N, Ryningen A, Ulvestad E.